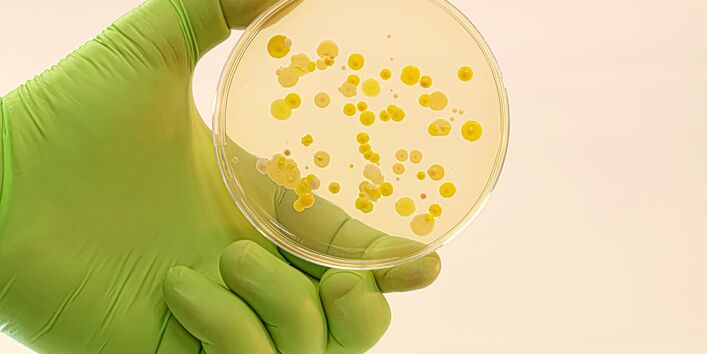
Nahaufnahme von Bakterienkolonien auf einem Nährboden in einer Petrischale

Das Quiz zu Antibiotika – mitmachen und gewinnen!
Testen Sie ihr Wissen und gewinnen Sie anlässlich der World AMR Awareness Week – Aktionswoche zu Antibiotikaresistenzen vom 18. bis 24.11.2024 – einen von 50 Geburtstagskalendern! Wissen Sie, welche “Nebenwirkungen“ Antibiotika in der Umwelt haben? Wollten Sie schon immer erfahren, was die Verbreitung von Antibiotikaresistenzen damit zu tun hat? Dann schauen Sie in unsere FAQ!
Vom 18. November bis zum 24. November jährt sich, seit 2015, die internationale Aktionswoche World AMR Awareness Week (WAAW). Dabei handelt es sich um eine weltweite Kampagne zur Bekämpfung von Antibiotikaresistenzen (AMR, antimicrobial resistance) – eine der größten Gesundheitsgefahren unserer Zeit.
Wenn ein Antibiotikum seine Wirkung verliert, ist prinzipiell jeder gefährdet. Infektionen mit resistenten Erregern lassen sich meist schwieriger behandeln und können einen komplizierten Verlauf nehmen. Ein erhöhtes Risiko für solche Infektionen haben insbesondere Menschen mit einem schwachen Immunsystem, Kinder und ältere Menschen
Die Entstehung von Antibiotikaresistenzen kann zwar nicht verhindert, die Verbreitung aber mit den richtigen Maßnahmen „eingedämmt“ bzw. verlangsamt werden. Aktuell ist die Gefahr jedoch noch nicht gebannt und Antibiotikaresistenzen nehmen weltweit zu. Sie sind eine der größten Herausforderungen für die globale Gesundheit dieser Zeit.
Um auf dieses Problem aufmerksam zu machen, findet jedes Jahr im November die WAAW statt, um das Bewusstsein und das Verständnis für Antibiotikaresistenzen zu verbessern. Die Woche soll alle Verantwortlichen ermutigen, Antibiotika umsichtig einzusetzen und Präventivmaßnahmen zur Bekämpfung von Antibiotikaresistenzen gemeinsam zu stärken.
Auch die Umwelt spielt bei der Entstehung und Verbreitung von Antibiotikaresistenzen eine Rolle. Welche das ist, erfahren Sie in unserer FAQ: Antibiotika und Antibiotikaresistenzen in der Umwelt. Am Ende der Seite können Sie Ihr neues Wissen mit einem kleinen Quiz zum Download testen. Bei korrekter Lösung erscheint im Quiz der Link zur Verlosung. Unter allen richtigen Lösungen verlosen wir bis zum 09.12.2024 zum 50. Geburtstag des UBA insgesamt 50 exklusive Geburtstagskalender im DIN A4-Format zum Thema Arzneimittel und Umwelt.
Machen Sie mit – gemeinsam gegen Antibiotikaresistenzen!
Hinweise zur Verlosung: Bei mehr als 50 eingehenden korrekten Lösungen, entscheidet das Los über die Gewinner. Teilnahme ab 16 Jahren. Mitarbeitende des Umweltbundesamtes und deren Angehörige sind für die Teilnahme nicht zugelassen. Eine Mehrfachteilnahme ist untersagt. Der Versand der Geburtstagskalender erfolgt nur innerhalb Deutschlands. Es entstehen Ihnen keine Zusatzkosten. Der Rechtsweg ist im Hinblick auf die Bestimmung der Gewinner und die etwaige Beurteilung der eingereichten Gewinnspielbeiträge ausgeschlossen.